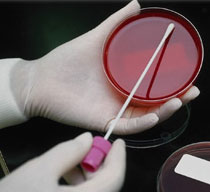

PENDARAHAN SELEPAS MELAKUKAN HVS
“Salam doktor. Saya mengalami keputihan sehingga bertukar warna kekuningan. Kemudian saya buat HVS pagi semalam tadi. Sebelum magrib tadi saya dapati lendir saya bercampur darah. Adakah darah ini disebabkan swab tadi? Mohon penerangan doktor. Terima kasih”
WA ALAIKUM MUS SALAM
High Vaginal Swab (HVS) adalah teknik yang digunakan di Jbatan Obstetrics & Gynaecology untuk mengambil contoh sampel lendiran dalam faraj. Ia diambil di bahagian berdekatan dengan pangkal rahem.
Sampel lendiran ini akan dihantar untukujian “ culture and sensitivity” untuk memeriksa punca jangkitan pada faraj.
Selalunya dilakukan apabila doctor mengesyaki ada jangkitan candidiasis, bacterial vaginosis atau trichomonas vaginalis.
Oleh kerana kawasan tersebut dijangkiti kuman dan berada dalam keadaan radang, sentuhan dari swab mungkin akan menyebabkan pendarahan yang minima.
Jika pendarahan itu tidak berhenti dalam masa 3 hari, saya menasihatkan puan menjalani pemeriksaan semula.
Wallahu a’lam.
IKLAN
Bagi wanita yang mengalami masalah kitaran haid yang tidak menentu, dan bagi wanita yang baru melahirkan anak, saya mencadangkan suplemen , selain dari vitamin C dan E. Boleh dapatkan produk Kacip Fatimah keluaran UTM di http://needsvenue.com.my
Bagi individu yang mengalami parut dan kekeringan kulit, terutamanya eczema saya mencadangkan cream Labicea Revitalizing Moisturizer. Info lanjut di https://www.facebook.com/Labicea-Revitalizing-Moisturizer-486696818067490/
Untuk pembelian menggunakan kad kredit sila klik di bawah:

 Dr Zubaidi Hj Ahmad Menulis Perkongsian Pengetahuan dan Pengalaman
Dr Zubaidi Hj Ahmad Menulis Perkongsian Pengetahuan dan Pengalaman